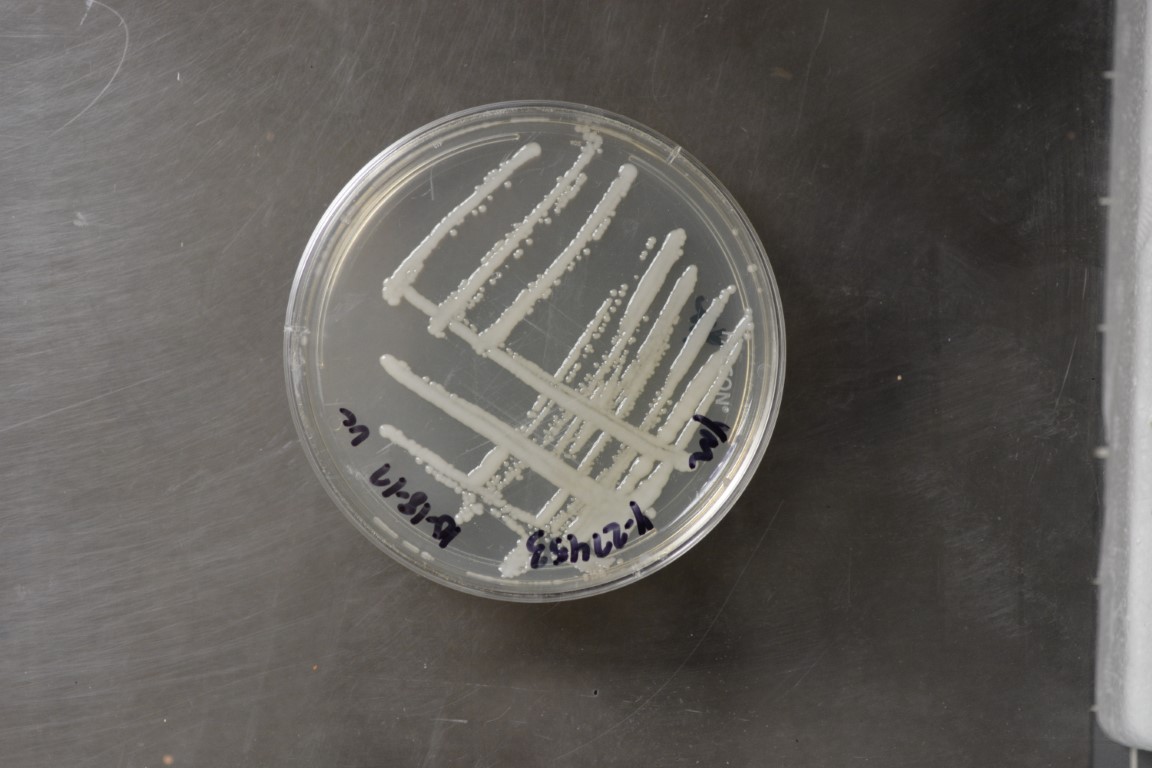

Metschnikowia hibisci
NRRL Y-27453(Type Strain)
Accession numbers in other collections:CBS 8433=UWO(PS)95-797.2
Source:A.Lachance,Dept.of Plant Sciences,Univ.of Western Ontario,Canada
Isolated from(substrate):IN,fruit fly,Drosophila hibisci on rosella flower,Hibiscus heterophyllus(yellow)
Substrate location:Byfield State Forest,Queensland,Australia
Genetic info:GenBank:D1/D2(AF034128).
Growth media:Yeast Extract-Malt Extract-Peptone-Glucose(YM for yeasts)(number 6)
Optimum growth temperature:25C
Strain images:
NRRL_Y-27453_6.JPG

Comments:Can J Microbiol 44:279-288(1998).